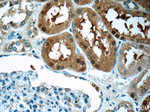
SNAPC5 Antibody in Immunohistochemistry (Paraffin) (IHC (P))

Search
Proteintech
SNAPC5 Polyclonal Antibody
{{$productOrderCtrl.translations['antibody.pdp.commerceCard.promotion.promotions']}}
{{$productOrderCtrl.translations['antibody.pdp.commerceCard.promotion.viewpromo']}}
{{$productOrderCtrl.translations['antibody.pdp.commerceCard.promotion.promocode']}}: {{promo.promoCode}} {{promo.promoTitle}} {{promo.promoDescription}}. {{$productOrderCtrl.translations['antibody.pdp.commerceCard.promotion.learnmore']}}
产品信息
17272-1-AP
种属反应
宿主/亚型
分类
类型
抗原
偶联物
形式
浓度
规格
纯化类型
保存液
内含物
保存条件
运输条件
产品详细信息
Immunogen sequence: MLSRLQELR KEEETLLRLK AALHDQLNRL KMLVHVDNEA SINQTTLELS TKSHVTEEEE EEEEEESDS (1-68 aa encoded by BC014315)
靶标信息
Part of the SNAPc complex required for the transcription of both RNA polymerase II and III small-nuclear RNA genes. Binds to the proximal sequence element (PSE), a non-TATA-box basal promoter element common to these 2 types of genes. Recruits TBP and BRF2 to the U6 snRNA TATA box.
仅用于科研。不用于诊断过程。未经明确授权不得转售。
篇参考文献 (0)
生物信息学
蛋白别名: Small nuclear RNA-activating complex polypeptide 5; SNAPc 19 kDa subunit; SNAPc subunit 5; snRNA-activating protein complex 19 kDa subunit; snRNA-activating protein complex subunit 5; unnamed protein product
基因别名: SNAP19; SNAPC5
UniProt ID: (Human) O75971
Entrez Gene ID: (Human) 10302